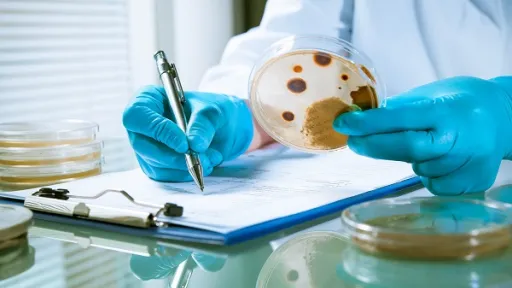

În perioada 18-24 noiembrie, este marcată Săptămâna mondială de conștientizare a rezistenței la antimicrobiene, care are drept scop informarea populației referitor la utilizarea rațională și prudentă a acestor medicamente, utilizate pentru prevenirea și tratarea infecțiilor.
Sloganul săptămânii din acest an, la fel ca și în anul precedent este „Să prevenim rezistența la antimicrobiene împreună”. Utilizarea excesivă a antibioticelor, care sunt preparate antimicrobiene, fac ca bacteriile, care se modifică în timp, să nu mai răspundă la medicamente. Astfel infecțiile devin și mai greu de tratat, iar în acest mod crește riscul bolilor severe și a deceselor. Amenințarea pentru sănătatea populației în contextul rezistenței la antimicrobiene este determinată de consumul excesiv al acestor medicamente.
În Republica Moldova există Programul național pentru supravegherea și combaterea rezistenței la antimicrobiene pentru anii 2023-2027, care a fost aprobat, anul acesta, de Guvern, la inițiativa Ministerului Sănătății. Documentul presupune armonizarea cadrului normativ existent, elaborarea noilor acte în domeniul rezistenței la antimicrobiene, în conformitate cu cerințele legislației Uniunii Europene și Organizației Mondiale a Sănătății referitor la utilizarea responsabilă a medicamentelor antimicrobiene.
Principalele obiective ale programului includ: consolidarea mecanismelor de introducere pe piață, prescriere și eliberare a acestor preparate, conform standardelor internaționale în domeniu, sporirea gradului de conștientizare atât în rândul populației, cât și în rândul specialiștilor din domeniul sănătății, cu privire la rezistența la antimicrobiene. În scopul atingerii obiectivelor, vor fi desfășurate acțiuni de dezvoltare a programelor informativ-explicative orientate către populație, de monitorizare a circulației pe piață a antimicrobienelor și de monitorizare a consumului acestor preparate, inclusiv la nivelul instituțiilor medicale, pentru prescrierea rațională a medicamentelor antimicrobiene. Acțiunile prevăzute în program sunt aliniate la obiectivul „O singură sănătate”, în vederea asigurării principiilor Organizației Mondiale a Sănătății.
Infecțiile provocate de bacteriile rezistente la preparatele antimicrobiene cauzează anual 25 de mii de decese în Uniunea Europeană și 700 de mii de decese la nivel mondial. În anul 2022, Comisia Europeană, împreună cu statele membre, a identificat rezistența la antimicrobiene ca fiind una dintre cele trei amenințări prioritare la adresa sănătății în UE. Principalii factori ai rezistenței la aceste preparate țin de utilizarea necorespunzătoare și administrarea excesivă a acestor medicamente.
Rezistența la antimicrobiene ne afectează pe toți, iar efortul global de informare a populației referitor la utilizarea responsabilă a acestor preparate vine în contextul consolidării prevenirii și controlului infecțiilor. Împreună putem contribui la menținerea eficacității tratamentelor antimicrobiene și protejarea sănătății publice.